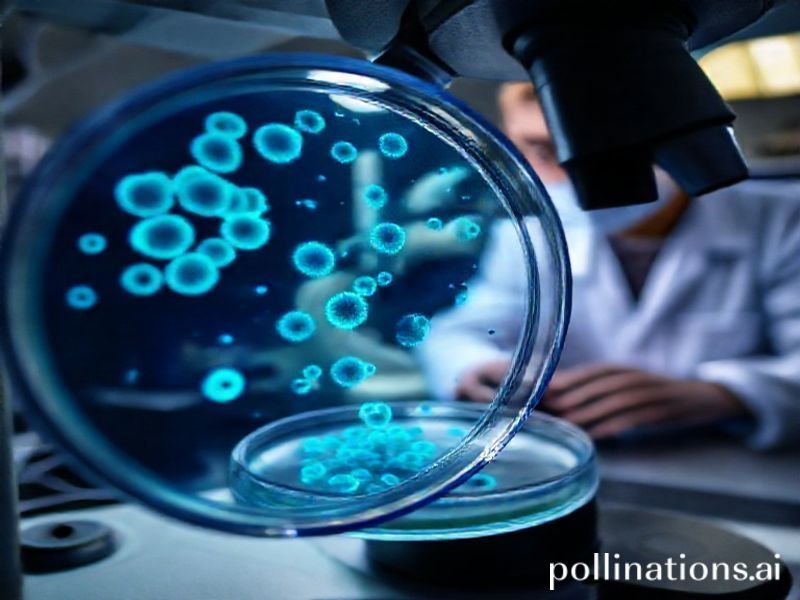
Trending: neuroblastoma cancer

Neuroblastoma: The Cancer That’s Got the World Talking (And Fighting)
Neuroblastoma: The Cancer That’s Got the World Talking (And Fighting)
If you’ve been scrolling through your social media feeds lately, you might have noticed a surge in posts about neuroblastoma. It’s not just another medical term trending because of a celebrity diagnosis (though, sadly, that’s part of it). Neuroblastoma has become a global talking point, sparking conversations about childhood cancer, medical research, and the power of community activism. So, why is this particular cancer making waves across the internet? Let’s dive in.
What Is Neuroblastoma?
First, let’s get the basics out of the way. Neuroblastoma is a type of cancer that primarily affects young children, often under the age of five. It develops from immature nerve cells and can appear in various parts of the body, including the adrenal glands, chest, spine, or even the brain. Unlike many adult cancers, neuroblastoma is aggressive and can spread rapidly, making early detection and treatment crucial.
Why Is It Trending Now?
Celebrity Influence and Awareness Campaigns
The recent trending of neuroblastoma can be partly attributed to high-profile cases. For instance, the diagnosis of a young child of a well-known public figure brought global attention to the disease. When celebrities or influencers share their personal struggles, it humanizes the issue and amplifies awareness. Suddenly, neuroblastoma isn’t just a medical term in a textbook—it’s a fight that resonates with people worldwide.
Social Media Activism
Social media has become a powerful tool for raising awareness and funds for causes. Hashtags like #NeuroblastomaAwareness and #FightNeuroblastoma have been trending, with users sharing stories, fundraising efforts, and calls to action. The internet’s ability to mobilize communities quickly has turned neuroblastoma into a viral topic, with people from all corners of the globe uniting to support research and treatment.
The Cultural Impact of Childhood Cancer
Childhood cancer is a heart-wrenching topic that cuts across cultural and geographical boundaries. When a child is diagnosed with a disease like neuroblastoma, it strikes a chord with people everywhere. The innocence of childhood juxtaposed with the brutality of cancer creates a powerful emotional response, driving people to take action. Social media campaigns, charity events, and online fundraisers have all contributed to the global conversation around neuroblastoma.
The Significance of the Trend
Funding and Research
One of the most significant outcomes of neuroblastoma’s trending status is the increased funding and research dedicated to finding a cure. Organizations like the Children’s Neuroblastoma Cancer Foundation and the American Cancer Society have seen a surge in donations and support. The more people talk about neuroblastoma, the more resources are allocated to research, bringing us closer to better treatments and, hopefully, a cure.
Community and Support
The internet has a unique way of bringing people together. Online communities have formed around neuroblastoma, providing support for families affected by the disease. From Facebook groups to Reddit forums, these spaces offer a lifeline for those navigating the challenges of childhood cancer. The trending nature of neuroblastoma has strengthened these communities, ensuring that no one has to face the battle alone.
Education and Advocacy
Awareness is the first step toward change. As neuroblastoma trends globally, more people are educated about the disease, its symptoms, and the importance of early detection. This knowledge empowers individuals to advocate for better healthcare policies, increased funding, and improved access to treatment. The more we talk about neuroblastoma, the more we can do to combat it.
Conclusion
Neuroblastoma’s rise to trending status is a testament to the power of awareness, community, and collective action. From celebrity influence to social media activism, the global conversation around this disease has brought hope and support to countless families. While the journey to finding a cure is far from over, the increased attention and funding are steps in the right direction. So, let’s keep the conversation going—because every share, every donation, and every act of kindness brings us one step closer to a world without neuroblastoma.